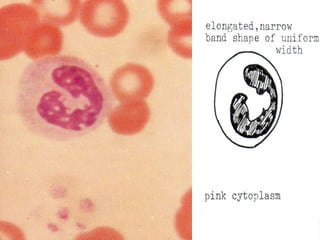
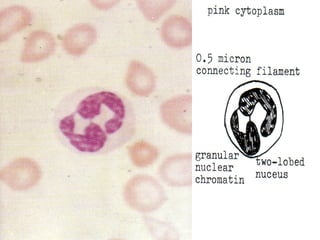

The document summarizes hematopoiesis, the process by which blood cells are formed from stem cells in the bone marrow. It discusses that hematopoiesis occurs through the simultaneous, continuous proliferation and differentiation of pluripotent stem cells in the bone marrow and lymphatic tissues. The structural organization of the hematopoietic marrow is also described, including the blood vessels, stroma, sinusoids, and cell types involved in hematopoiesis. The stages of development from stem cells to mature blood cells are outlined for erythropoiesis, granulopoiesis, monocytopoiesis, and thrombocytopoiesis.